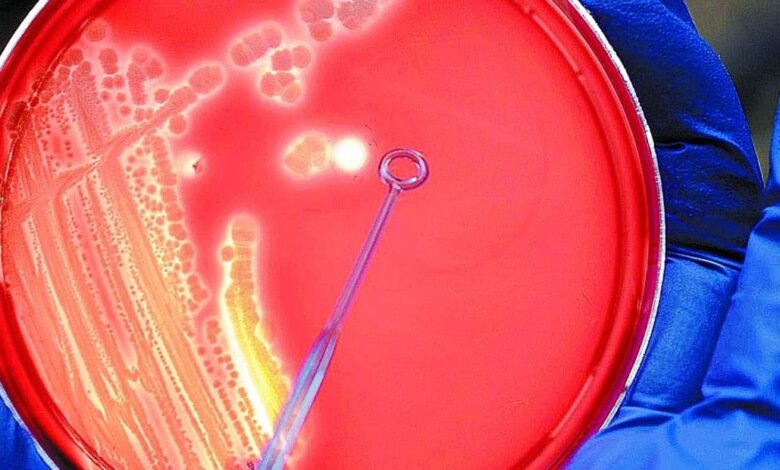

cómo es el plan contrarreloj para frenar a las superbacterias
El progreso del ser humano contiene en sí mismo el germen de su posible destrucción. La frase apocalíptica propone un desafío: advertir el peligro para controlarlo. Los antibióticos y su abuso son un ejemplo de esa amenaza. Otra podría ser la inteligencia artificial. Herramientas que surgen para ofrecer una solución y conducen a una encrucijada: la expectativa de más y mejor vida hasta que aflora el lado siniestro.
Robb Butler, director de la División de Enfermedades Transmisibles, Medio Ambiente y Salud de la Organización Mundial de la Salud (OMS), acaba de afirmar que con una actuación rápida, podría evitarse “un desenlace desastroso”. Y agregó: “A menudo se hace referencia a la resistencia a los antimicrobianos (RAM) como la ‘pandemia silenciosa’, pero sólo es silenciosa mientras nosotros permitamos que lo sea”.
La RAM es consecuencia del abuso de los antibióticos. “Tenemos que asistir a los países para usar los fármacos de una manera responsable. Podemos producir nuevos antibióticos, pero no es sólo una cuestión de innovar: si no corregimos la prescripción y los diagnósticos de laboratorio a nivel de los países, vamos a perder esos fármacos tan pronto estén disponibles”, dijo recientemente al sitio Medscape Kitty van Weezenbeek, directora de Vigilancia, Prevención y Control de la Resistencia Antimicrobiana de la OMS.
Las infecciones bacterianas se asocian a más de 7 millones de muertes en el mundo por año. Pero casi 1,3 millón de ese total fue resultado directo de bacterias resistentes a los medicamentos, según estadísticas de los Institutos Nacionales de la Salud de Estados Unidos.
Los antimicrobianos son medicamentos que se utilizan para tratar las infecciones causadas por bacterias, parásitos, hongos y virus. Y la resistencia aparece cuando esos microorganismos mutan o se adaptan como resultado de la exposición inadecuada a los antimicrobianos, de manera que se vuelven resistentes a ellos.
Argentina no escapa a la preocupación mundial y desde este año, la epidemióloga Rachel Mann Smith dirige una oficina con un equipo de expertos de los Centros para el Control y Prevención de Enfermedades (CDC), de Estados Unidos, que promueven la seguridad sanitaria mundial y la cooperación con los distintos países. Eso se suma a la aplicación por ley del Plan Nacional de Acción para el Control de la Resistencia a los Antimicrobianos.
Detectives de superbacterias
Mientras esa tarea preventiva se desarrolla, la ciencia también avanza para intentar dar respuestas a la RAM. Un trabajo exhaustivo está ocurriendo en la Clínica Mayo de Estados Unidos. Cómo “detectives de bacterias”, los investigadores ponen el foco en descubrir esas potenciales nuevas superbacterias que podrían ser una amenaza para la humanidad.
¿Cómo lo hacen? Creando una biblioteca extensa de prototipos de ADN de especies bacterianas patógenas, que sirve como base de datos de referencia para ayudar a los médicos a dar diagnósticos certeros y rápidos, y a precisar tratamientos dirigidos a fin de mejorar la recuperación de los pacientes.
“El desafío se vuelve mayor con el avance de la crisis de resistencia a los antibióticos”, aseguró Robin Patel, directora del Laboratorio de Investigación de Enfermedades Infecciosas de la Clínica Mayo. La base de datos bacteriana contiene más de 1.200 secuencias de ADN de especies bacterianas recuperadas de zonas infectadas, como pulmones, orina, articulaciones y sangre. “No sólo muchas no habían sido secuenciadas, sino que algunas ni siquiera tenían nombre”, agregó Patel.
Los científicos han nombrado y descrito aproximadamente a 10 mil especies bacterianas, pero eso es sólo una fracción mínima de la diversidad total de bacterias que se encuentran en todos los hábitats del planeta: microbios minúsculos de un décimo del diámetro de un cabello humano, con una pared protectora gruesa que les permite sobrevivir en entornos hostiles, incluido el intestino y el torrente sanguíneo humanos.
Una vista 3D de las bacterias que pueden habitar en el intestino delgado. Otras se vuelven una amenaza. Foto: Shutterstock.Muchas células bacterianas son beneficiosas para el cuerpo humano, pero otras causan enfermedades. Patel aseguró que conocer la composición genómica de cada cepa bacteriana permite comprender tanto su estructura y funcionamiento como lo que provoca que surja una cepa resistente a los medicamentos.
Con tecnologías de secuenciación de punta, Patel y su equipo también avanzaron en otro aspecto clave de la pesquisa: decodifican y mapean el ADN bacteriano directamente desde la muestra de pacientes. Eso posibilita la identificación precisa de la bacteria específica de la infección, como guía para los planes de tratamiento personalizados.
Los métodos convencionales implican días de cultivo y crecimiento bacteriano en una placa de Petri y, luego, la identificación. Mientras tanto, a los pacientes se les da uno o más antibióticos con la esperanza de erradicar las bacterias nocivas, a pesar de que los médicos puedan no saber exactamente cuáles son esas bacterias o siquiera si hay bacterias. Todo ello contribuye a la resistencia antimicrobiana.
Según Patel, su equipo se enfrenta frecuentemente con especies bacterianas resistentes a los medicamentos, y no sólo las más habituales, entre las que se encuentran Staphylococcus aureus, Streptococcus pneumoniae, Escherichia coli y Pseudomonas aeruginosa.
“Las bacterias tienen la capacidad de mutar por sí solas o de adquirir genes resistentes de otras bacterias. Hay cientos de especies diferentes de bacterias que pueden infectar a los pacientes, y es importante tener los datos para brindar asistencia médica a todos nuestros pacientes, incluso si están infectados por bacterias poco habituales o tienen infecciones complicadas”, sumó Patel.
Cultivo de bacterias resistentes a antibióticos.Colaboración contra las superbacterias
La alimentación de bases de datos abiertas, desde diferentes lugares del mundo, es clave para el combate contrarreloj de las superbacterias, con el objetivo de catalogarlas, verles la cara y ponerles nombre y apellido. Con ese objetivo, Argentina y Estados Unidos han generado un lazo científico estrecho desde antes de la irrupción de la pandemia de Covid.
A partir de 2019 rige un acuerdo de colaboración entre los CDC de ese país y el Instituto Malbrán, a partir del cual vienen trabajando en conjunto para ampliar la denominada red MicrobeNet, una biblioteca en línea de bacterias y hongos raros emergentes que permite el acceso en tiempo real para identificar una gran cantidad de infecciones raras.
Todos estos logros, que se hamacan entre la esperanza y la ilusión de que la ciencia logre mantener a las superbacterias bajo supervisión y control, vienen siendo posibles gracias a la espectrometría de masas, a través de la tecnología MALDI-TOF, que revolucionó la microbiología clínica en el siglo 21.
El valor de ese dispositivo es permitir el acceso a diagnósticos de muy alta precisión en tiempo récord. En Argentina, ya hay más de 30 instituciones de salud que poseen la herramienta y se han vuelto eslabones clave en la configuración de la base de datos global. Tal vez sea la biblia que contribuya, contra toda pulsión autodestructiva, a la supervivencia inverosímil del ser humano.
Source link



